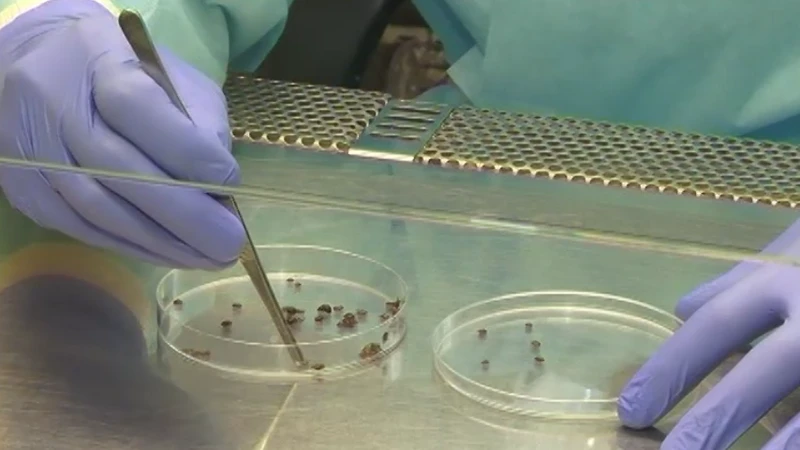

15 зараженных энцефалитом и боррелиозом клещей выявили в лабораториях Оренбуржья
По последним данным Роспотребнадзора, в медицинские организации Оренбургской области обратились 369 человек с укусами клещей, среди них — 147 детей. Случаи присасывания клещей зафиксированы в большинстве районов и городов региона. На данный момент заболеваний клещевым вирусным энцефалитом и иксодовым клещевым боррелиозом не зарегистрировано, но лабораторные исследования подтверждают наличие потенциальной угрозы. Из 974 изученных клещей выявлено 14 экземпляров с признаками иксодового клещевого боррелиоза и 1 клещ с признаками вирусного энцефалита.
В связи с активностью клещей оренбуржцам необходимо соблюдать меры предосторожности на природе:
- носить одежду, плотно прилегающую к телу — это затруднит проникновение клещей;
- использовать специальные средства, отпугивающие клещей;
- каждые 15–20 минут проводить само и взаимоосмотры на наличие клещей. Также важно регулярно осматривать домашних животных после прогулок на природе;
- при обнаружении присосавшегося клеща незамедлительно обратиться за медицинской помощью в поликлинику по месту жительства.
В Оренбургской области исследования клещей проводят платно в Центре гигиены и эпидемиологии. За подробной информацией можно обратиться по телефону: 8 (3532) 430749.